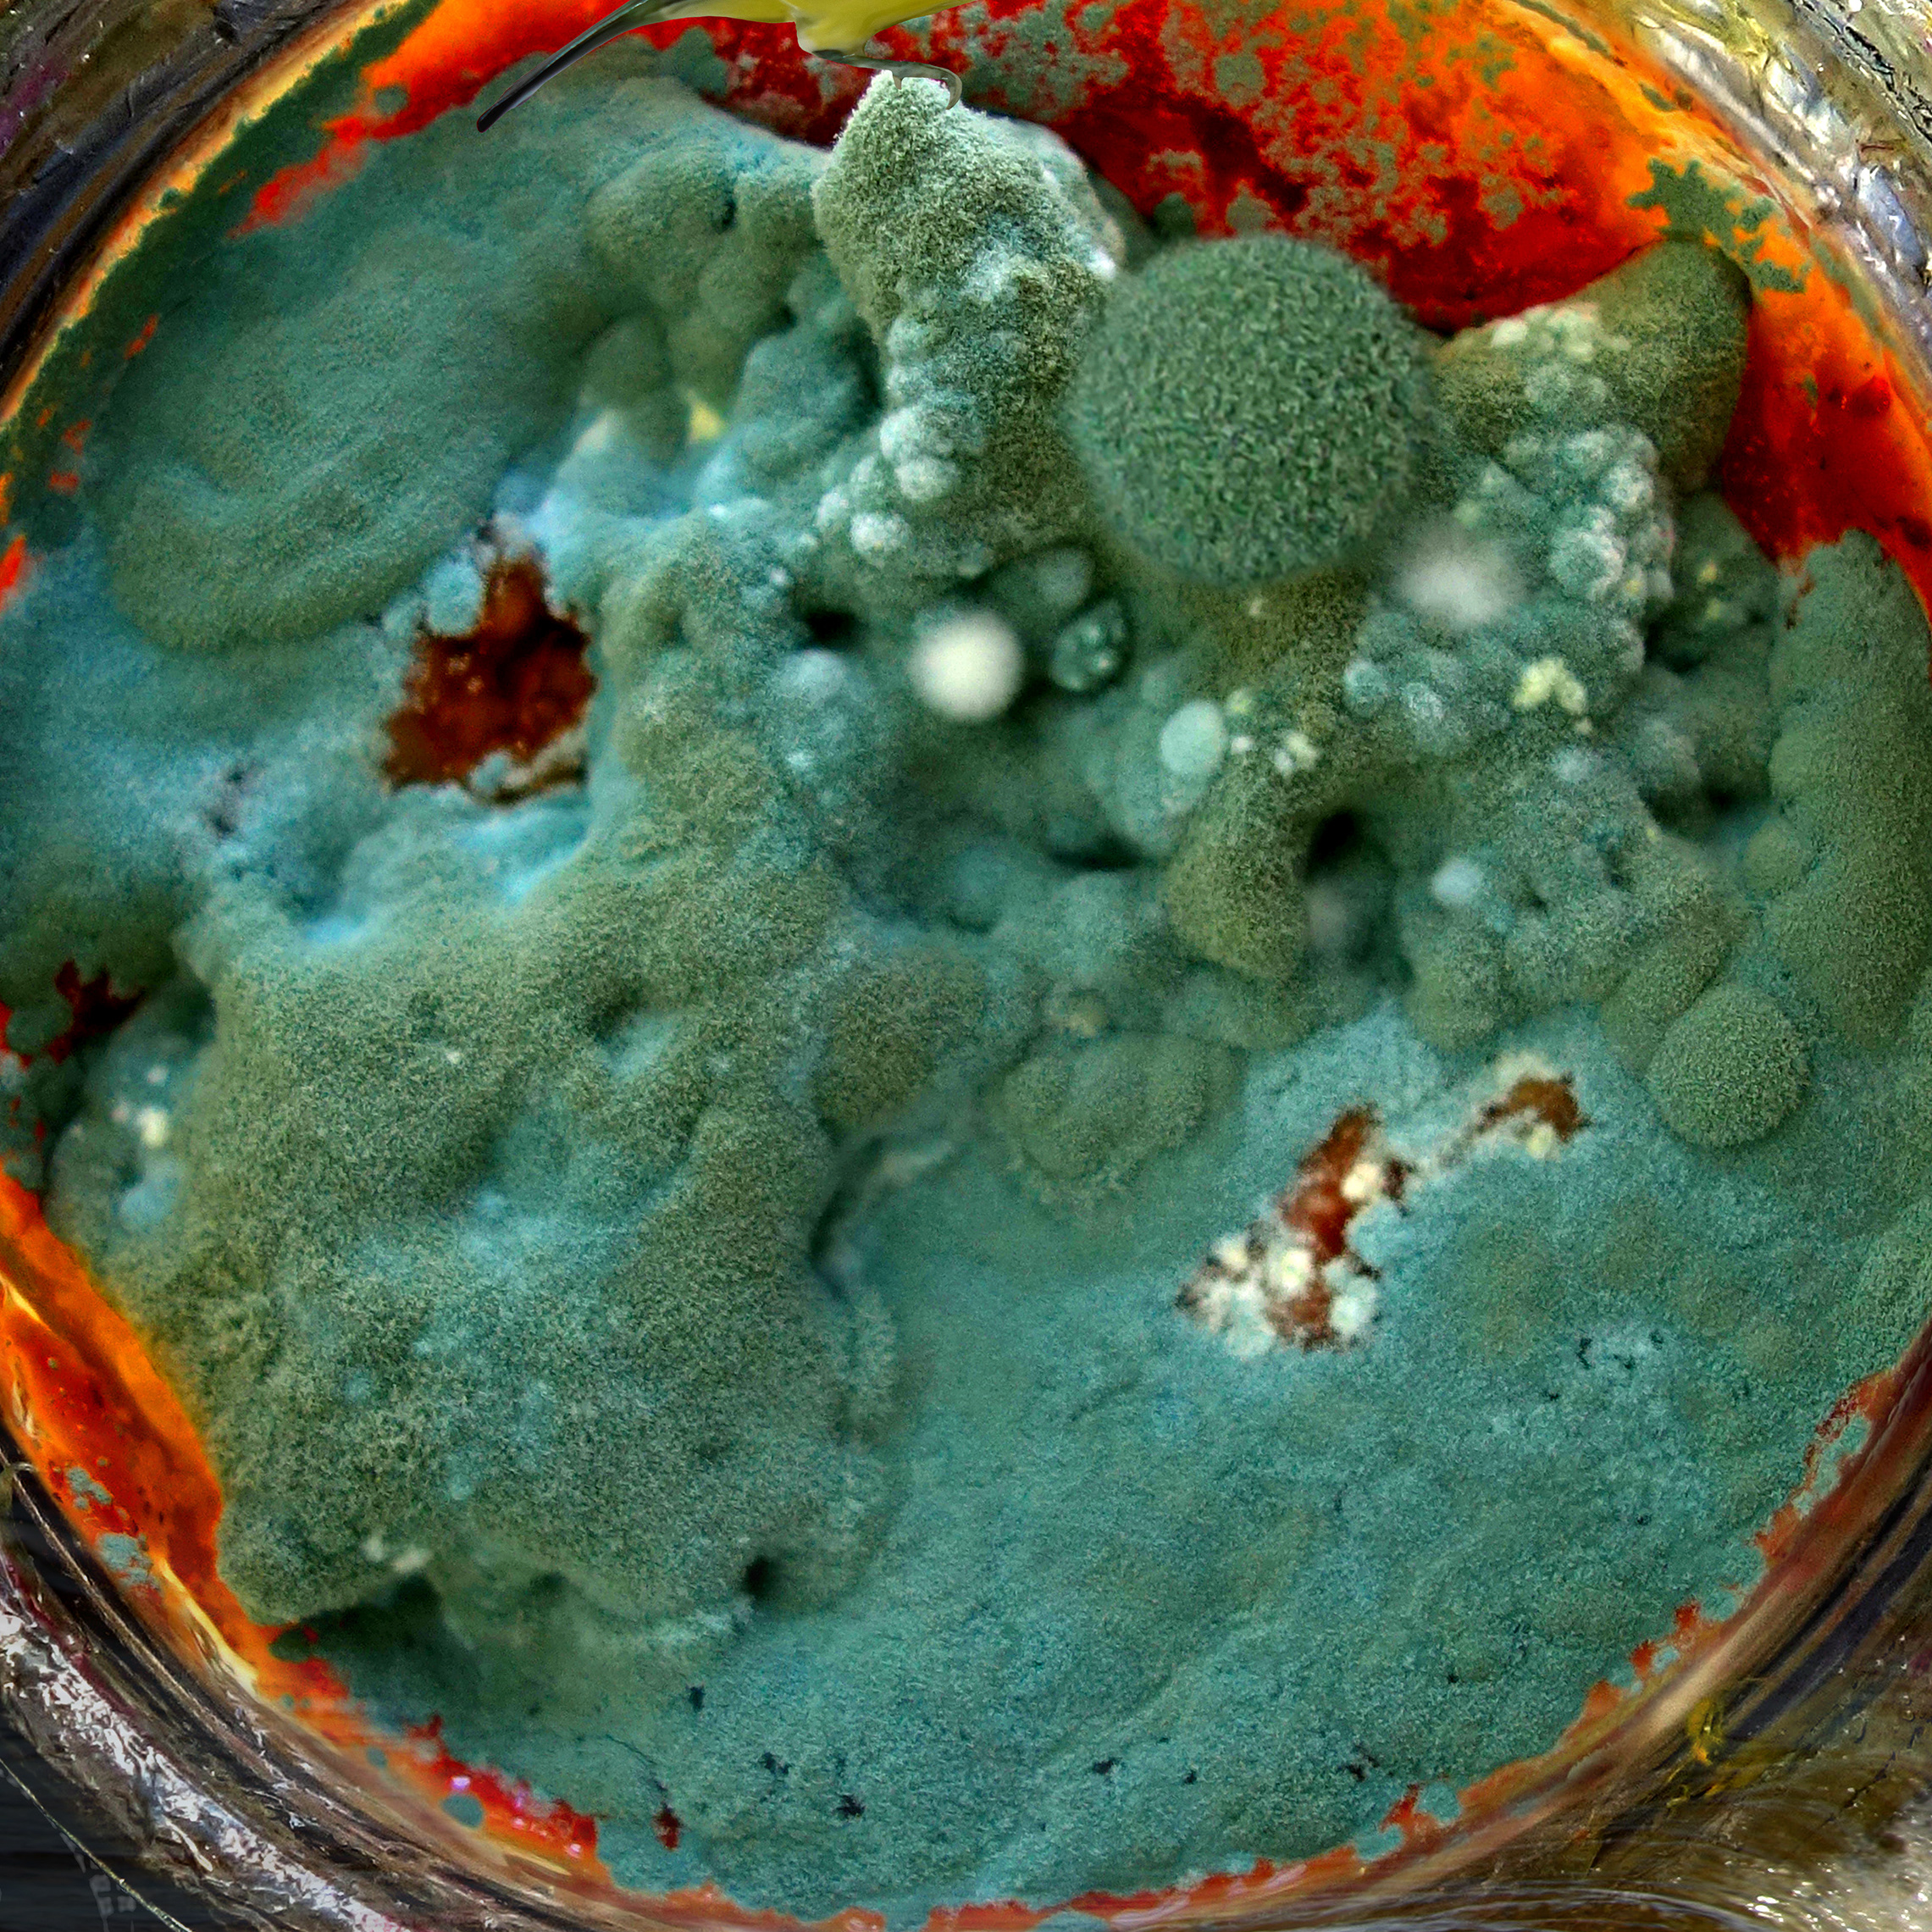

2026
À propos
2026
Recherche photographique

2026
Recherche picturale

2026
Littérature

2026
Sculpture et relief

2026
Art public

2026
Évènements

2026
CV